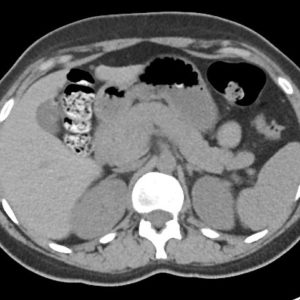
U tụy

TIÊU HOÁ
Hiển thị 1041–1060 của 1445 kết quảĐã sắp xếp theo mới nhất
-

Thủng túi thừa
Lượt xem: 188» 08-02-2019 -

Thoát vị nội
Lượt xem: 226» 08-02-2019 -

Túi thừa thực quản
Lượt xem: 214» 06-02-2019 -

Hamartoma đường mật
Lượt xem: 375» 06-02-2019 -

Dị vật ổ bụng
Lượt xem: 257» 06-02-2019 -

Dị vật ổ bụng
Lượt xem: 184» 06-02-2019 -

Dị vật ổ bụng
Lượt xem: 192» 06-02-2019 -

Dị vật ổ bụng
Lượt xem: 195» 06-02-2019 -

Túi mật sứ
Lượt xem: 317» 02-02-2019 -

Viêm túi mật
Lượt xem: 99» 02-02-2019 -

U cơ tuyến túi mật
Lượt xem: 623» 02-02-2019 -

Ung thư túi mật
Lượt xem: 629» 02-02-2019 -

Thủng túi thừa đại tràng
Lượt xem: 686» 28-01-2019 -

Túi thừa đại tràng chảy máu
Lượt xem: 633» 28-01-2019 -

Apxe quanh hậu môn
Lượt xem: 658» 28-01-2019 -

Viêm bờm mỡ đại tràng
Lượt xem: 389» 28-01-2019 -

U máu gan
Lượt xem: 688» 28-01-2019 -

Viêm túi thừa
Lượt xem: 716» 27-01-2019 -

U tụy
Lượt xem: 644» 27-01-2019 -

Thoát vị hoành
Lượt xem: 650» 26-01-2019